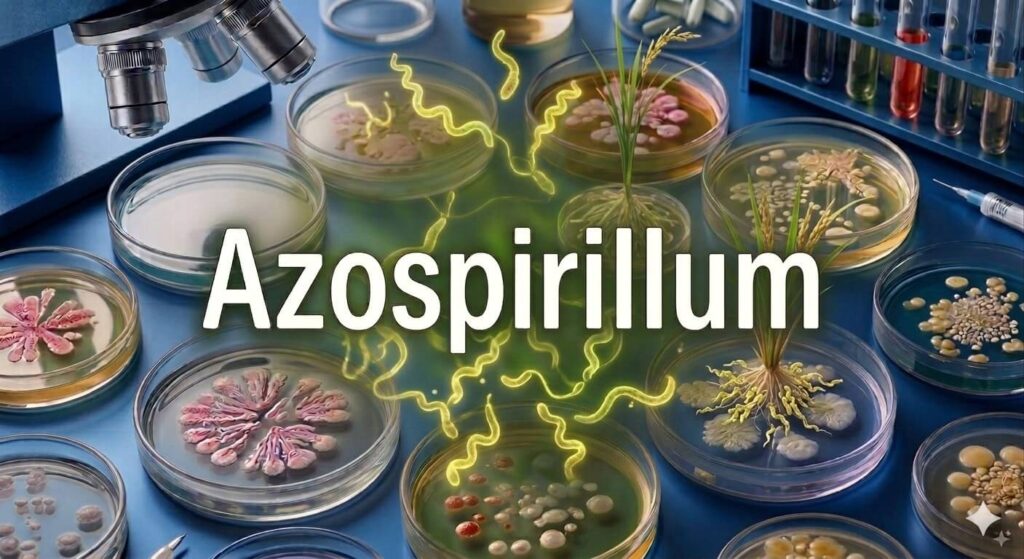
Azospirillum

In the world of soil microbes, every bacterium has its own personality. If some microbes form deep partnerships and others prefer working alone, Azospirillum is like the friendly neighbour who doesn’t move into your house but is always nearby, quietly helping. It stays close to plant roots, supports them, and somehow makes them grow better — even if you don’t immediately notice how.
What is Azospirillum
Azospirillum is known as an associative nitrogen-fixing bacterium. This means it does not form special nodules like Rhizobium, and it does not live completely independently like Azotobacter. Instead, it stays very close to plant roots in the rhizosphere — the thin layer of soil surrounding the roots. Sometimes it even enters the outer root tissues without causing any harm. This close relationship allows Azospirillum to use the natural sugars and nutrients released by roots as a source of energy.
Nitrogen Fixation: Only Part of the Story
One of its important abilities is nitrogen fixation. Like other nitrogen-fixing bacteria, it uses the enzyme nitrogenase to convert nitrogen gas from the air into ammonia, which plants can use. However, the amount of nitrogen fixed by Azospirillum is moderate compared to some other bacteria. Scientists noticed that plants treated with Azospirillum often grow much better than expected from nitrogen supply alone. This led to an important discovery — nitrogen fixation is only part of its story.
The Real Strength: Root Building Through Growth Hormones
The real strength of Azospirillum lies in its ability to produce plant growth hormones in large amounts. It releases high levels of Indole-3-Acetic Acid (IAA), a natural auxin that strongly influences root growth. When IAA is released near the roots, it changes the root structure in a remarkable way. Roots grow longer and thicker. They develop more side branches and many more root hairs. This creates a larger and more efficient root system. With more roots exploring the soil, the plant can absorb water and nutrients — including nitrogen, phosphorus, and potassium — much more effectively. In simple terms, Azospirillum does not just provide nutrients; it improves the plant’s ability to find nutrients on its own.
Other Growth Promoting Hormones
In addition to IAA, Azospirillum also produces other growth-promoting hormones such as gibberellins and cytokinins. These hormones help improve seed germination, stimulate shoot growth, and increase overall plant vigor. It also produces small amounts of nitric oxide, a signaling molecule that supports root development and helps plants respond better to stress conditions.
Crops and Field Performance
Azospirillum has shown consistent positive results in many crops, including wheat, maize, rice, sugarcane, and vegetables. Wheat and maize farmers have reported stronger root systems, better tillering, and improved grain filling. In rice, it supports early establishment and helps the crop handle stress during critical growth stages. Sugarcane benefits from its hormone production, which encourages taller and more vigorous stalks. Vegetable growers have seen faster germination, healthier seedlings, and more uniform crop stands.
What makes Azospirillum particularly practical for farmers is how easy it is to use. It is available commercially as a liquid or powder formulation and can be applied as a seed treatment before sowing, as a soil drench at planting, or as a root dip for transplanted crops. No special equipment is needed. No major changes to existing farming practices are required. A farmer who has never used a biofertilizer before can adopt Azospirillum without any difficulty.
Results are typically visible within a few weeks of application — roots look healthier, seedlings establish faster, and the overall crop appears more vigorous compared to untreated fields. Over multiple seasons, fields treated with Azospirillum tend to show gradual improvement in soil microbial activity and overall soil health.
Conclusion
Because it works with both legume and non-legume crops, Azospirillum is one of the most widely useful biofertilizers available today. Most biofertilizers are known for one specific crop or one specific nutrient. Azospirillum does not work that way — it fits naturally into almost any farming system and delivers benefits that go well beyond simple nitrogen supply, building roots, producing hormones, and quietly improving everything the plant needs to grow well.
For a farmer, the appeal is straightforward. You apply it once at sowing or planting and it gets to work immediately — without demanding anything extra or requiring any change in how you farm. In a time when every input cost matters and every kilogram of yield counts, having a biofertilizer that strengthens the plant from its roots upward, naturally and affordably, is not just useful — it is exactly the kind of quiet, dependable help that makes a real difference.